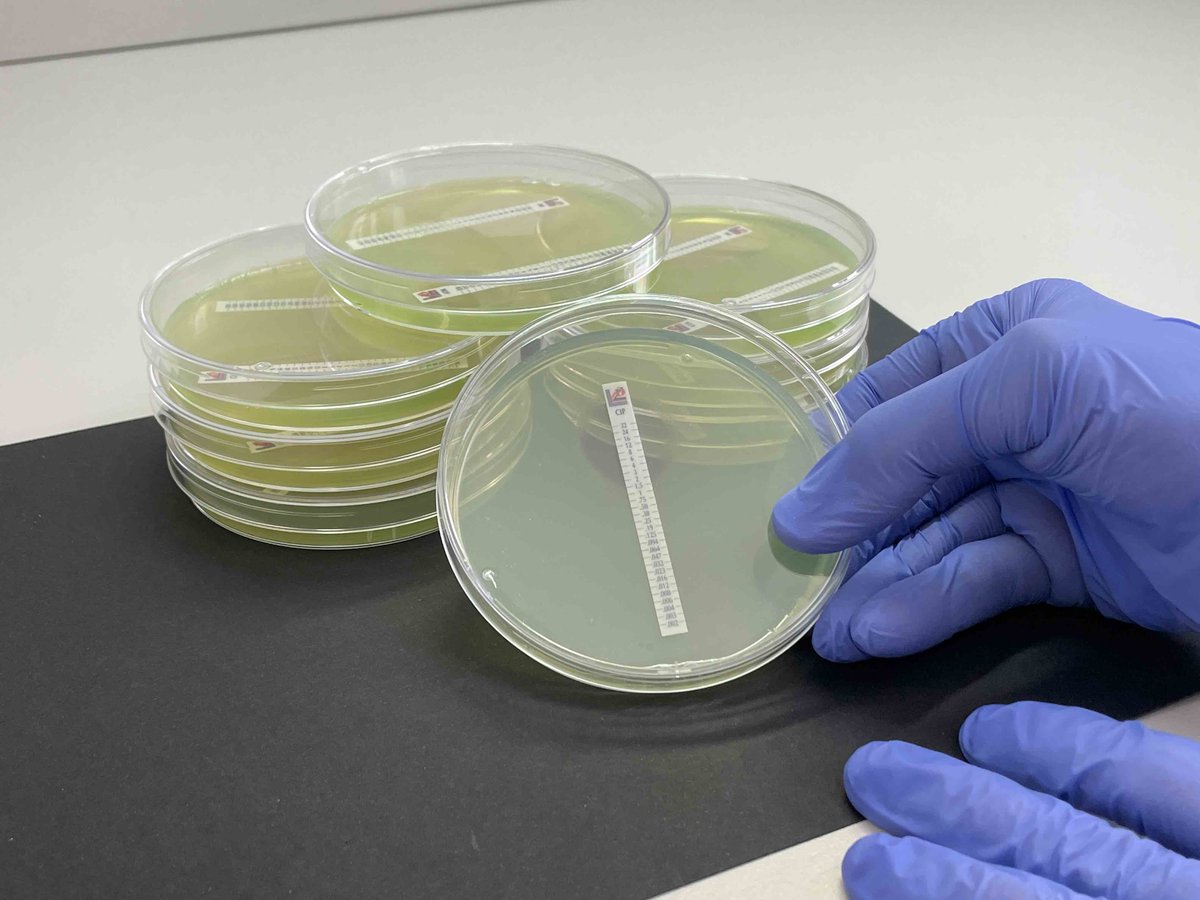

Centro Nacional de Biotecnología (CSIC)
@cnb_csic
Novedades desde el Centro Nacional de Biotecnología del CSIC (Madrid)
ID: 173735526
http://www.cnb.csic.es 02-08-2010 06:31:19
8,8K Tweet
29,29K Followers
846 Following

Esta tarde estaré en Oviedo, en el club de prensa asturiana La Nueva España a las 19:30, para hablar sobre #albinismo invitado por la delegación del CSIC en Asturias CSIC Asturias dentro del programa “¿Qué sabemos de…?” CSIC Divulga Centro Nacional de Biotecnología (CSIC) csic.es/es/agenda-del-…



📢Atención docentes, ¡este concurso sigue abierto! 👥Para estudiantes de 3º y 4º de ESO 📽️Haz un vídeo de máximo 3 minutos sobre los objetivos del proyecto europeo de investigación en terapia génica iAds iAds project ▶️Súbelo a YouTube 📤Envía el enlace antes del 15 de junio





We hosted a scientific meeting between #CNB_CSIC and representatives from the Shenzhen Institutes of Advanced Technology (SIAT), part of Chinese Academy of Sciences (CAS), along with the Guangdong Provincial Dept. of Science and Technology to advance #SyntheticBiology. bit.ly/4mReTmU


Conocemos los 4 proyectos ganadores de ayudas a la investigación Fundación Occident, liderados por Adrián A. Valli, Alberto Pascual, Sara Hernando y Eduardo González. 👥Presentan la jornada: Mario Mellado, director #CNB_CSIC) y Laura Halpern, presidenta del Patronato de F. Occident.



‼️LAST WEEK to submit Highlight Papers and Talks/Posters to the JBI2025 Calls close on 16 JUNE!! 👉buff.ly/0R0jBoK Centro Nacional de Biotecnología (CSIC) CNIO Stop Cancer INB / ELIXIR-ES @BioData_PT Instruct-ERIC


Our latest work is out in Nucleic Acids Res! 🚀 In collaboration with Silvia Ayora’s group Centro Nacional de Biotecnología (CSIC), we show that bacterial RecD2 binds long ssDNA, translocates 5′–3′ over >20 kb, and exhibits force-enhanced unwinding and strand switching at DNA forks. academic.oup.com/nar/article/53…

Las bacterias no siempre son perjudiciales, pero pueden llegar a serlo. Los premiados: El Dr. Daniel López Serrano, Científico Titular del CSIC en el Centro Nacional de Biotecnología (Centro Nacional de Biotecnología (CSIC)), y la Dra. Almudena R. Ramiro (Almudena Ramiro), profesora titular en el Centro

Very proud to have received the SECOT (voluntariado de asesoramiento empresarial) Excellence Award to the most impactful startup #Biodriven biodriventech.com. Well done Team!! POLYBIO Environmental Biotechnology Centro Nacional de Biotecnología (CSIC) IATA CSIC CIB Margarita Salas (CSIC)




Enhorabuena por estos 3 nuevos Advanced Grant European Research Council (ERC) que se desarrollarán en el #CSIC. El proyecto de Daniel López, Daniel Lopez del #CNB_CSIC estudiará elementos clave en la resistencia a los antibióticos 👏👏 Más info ⬇️

Hoy hemos estado junto a compañeras del Instituto de Ciencia de Materiales Madrid - CSIC y Instituto de Cerámica y Vidrio ICV-CSIC realizando la actividad divulgativa #EscapeRoad Científicas Nobel en el centro penitenciario de Soto del Real. Muchas gracias Solidarios por esta jornada tan valiosa.


👏👏Nuestra enhorabuena a la biofísica Eva Nogales The Nogales Lab, cátedra JAE-Chair en el #CNB_CSIC por este merecido reconocimiento. ¡Enhorabuena a ambos investigadores por esta distinción!